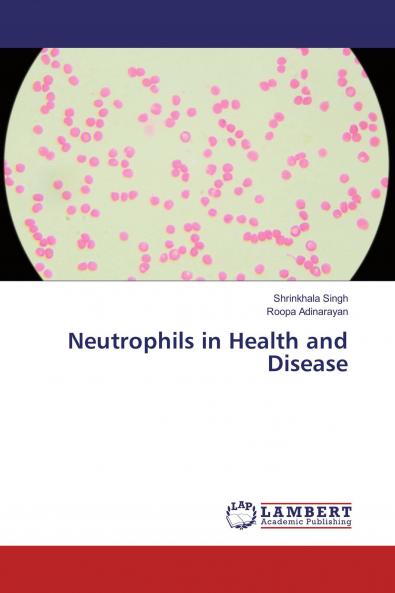
Neutrophils in Health and Disease

English
Paperback
₹3506
(All inclusive*)
Delivery Options
Please enter pincode to check delivery time.
*COD & Shipping Charges may apply on certain items.
Review final details at checkout.
Looking to place a bulk order? SUBMIT DETAILS
About The Book
Description
Author
Neutrophil is a first line of defence during inflammation. Role of Neutrophil exists during both in Health as well as in Disease. This book provides detailed knowledge about the formation Function and its role during Periodontal infection. They are mostly concerned with the medical aspect. There are very few books explaining its role in Dentistry. In this book knowledge has been provided about Neutrophils in Dentistry.
Delivery Options
Please enter pincode to check delivery time.
*COD & Shipping Charges may apply on certain items.
Review final details at checkout.
Details
ISBN 13
9783330033962
Publication Date
-18-01-2017
Pages
-84
Weight
-121 grams
Dimensions
-150x220x4.92 mm